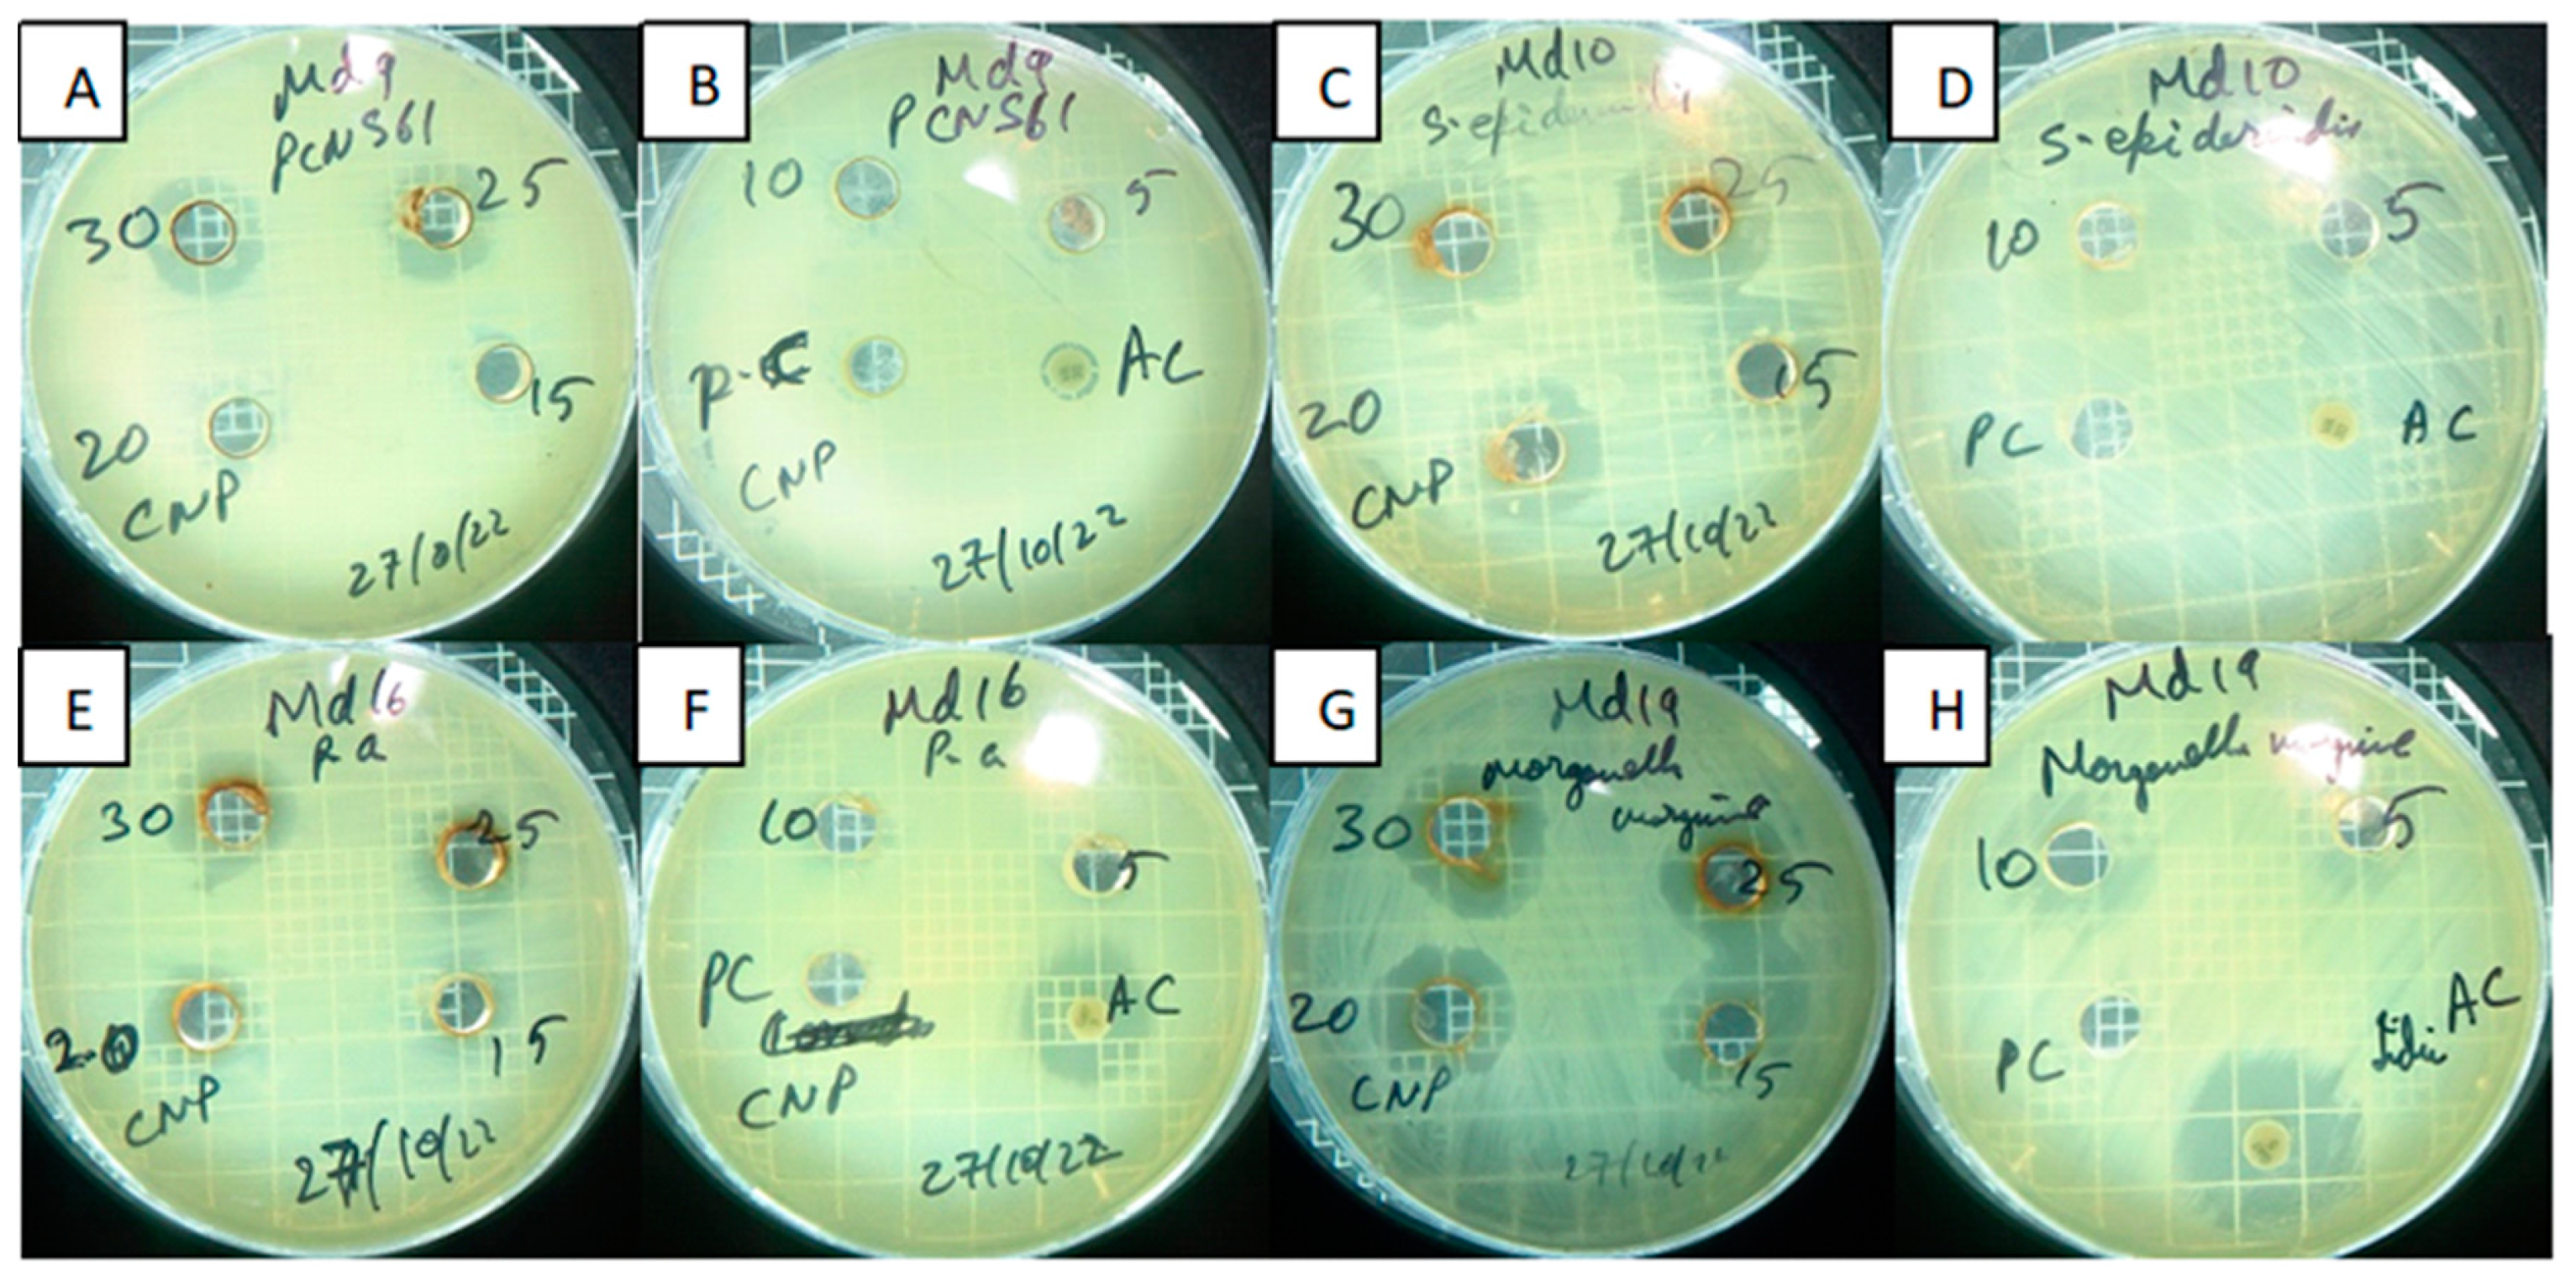
Catalysts 13 01290 g009

Silver Nanoparticles’ Biogenic Synthesis Using Caralluma subulata Aqueous Extract and Application for Dye Degradation and Antimicrobials Activities
Abstract
1. Introduction
2. Results and Discussion
2.1. Characterization and applications of Ag-CS NPs
2.2. Methylene Blue (MB) Dye Reduction Using Ag-CS NPs and NaBH4
2.3. Antimicrobial Sensitivity Testing (AST)
2.4. Discussion
3. Materials and Methods
3.1. Materials
3.2. The Botany of Caralluma subulate (CS) Slender and Preparation of Aqueous Extract
3.3. GC-MS Analysis of CS Slender Extract
3.4. Synthesis of CS-Slender Based Ag-CS NPs
3.5. Characterization of Ag-CS NPs
3.6. MB Dye Reduction Using Ag-CS NPs
3.7. Antimicrobial Sensitivity Testing
4. Conclusions
Supplementary Materials
Author Contributions
Funding
Data Availability Statement
Acknowledgments
Conflicts of Interest
References
- Haseena, M.; Malik, M.F.; Javed, A.; Arshad, S.; Asif, N.; Zulfiqar, S.; Hanif, J. Water pollution and human health. Environ. Risk Assess. Remediat. 2017, 1, 16–19. [Google Scholar] [CrossRef]
- Dayalan, S.; Gedda, G.; Li, R.N.; Zulfajri, M.; Huang, G.G. Vancomycin functionalization of gold nanostars for sensitive detection of foodborne pathogens through surface-enhanced Raman scattering. J. Chin. Chem. Soc. 2022, 69, 2049–2060. [Google Scholar] [CrossRef]
- Khan, M.S.; Gedda, G.; Gopal, J.; Wu, H.-F. Probing the cytotoxicity of CdS–MPA and CdSe–MUA QDs on the bacterial pathogen Staphylococcus aureus using MALDI-MS. Anal. Methods 2014, 6, 5304–5313. [Google Scholar] [CrossRef]
- Mandal, S.; Alankar, T.; Hughes, R.; Marpu, S.B.; Omary, M.A.; Shi, S.Q. Removal of hazardous dyes and waterborne pathogens using a nanoengineered bioadsorbent from hemp—Fabrication, characterization and performance investigation. Surf. Interfaces 2022, 29, 101797. [Google Scholar] [CrossRef]
- WHO. Guidelines for Drinking-Water Quality; World Health Organization: Geneva, Switzerland, 2002.
- Guo, Z.; Chen, Y.; Wang, Y.; Jiang, H.; Wang, X. Advances and challenges in metallic nanomaterial synthesis and antibacterial applications. J. Mater. Chem. B 2020, 8, 4764–4777. [Google Scholar] [CrossRef]
- Hutchings, M.I.; Truman, A.W.; Wilkinson, B. Antibiotics: Past, present and future. Curr. Opin. Microbiol. 2019, 51, 72–80. [Google Scholar] [CrossRef] [PubMed]
- Alaoui Mdarhri, H.; Benmessaoud, R.; Yacoubi, H.; Seffar, L.; Guennouni Assimi, H.; Hamam, M.; Boussettine, R.; Filali-Ansari, N.; Lahlou, F.A.; Diawara, I. Alternatives therapeutic approaches to conventional antibiotics: Advantages, limitations and potential application in medicine. Antibiotics 2022, 11, 1826. [Google Scholar] [CrossRef]
- Hasan, N.; Guo, Z.; Wu, H.-F. Large protein analysis of Staphylococcus aureus and Escherichia coli by MALDI TOF mass spectrometry using amoxicillin functionalized magnetic nanoparticles. Anal. Bioanal. Chem. 2016, 408, 6269–6281. [Google Scholar] [CrossRef]
- Lellis, B.; Fávaro-Polonio, C.Z.; Pamphile, J.A.; Polonio, J.C. Effects of textile dyes on health and the environment and bioremediation potential of living organisms. Biotechnol. Res. Innov. 2019, 3, 275–290. [Google Scholar] [CrossRef]
- Gandi, S.S.; Gandi, S.; Parne, S.R.; Lakavat, M.; Lakkimsetty, N.R.; Gedda, G. Bio-Inspired C/N/TiO2 Hybrid Composite Heterostructure: Enhanced Photocatalytic Activity under Visible Light. J. Nanotechnol. 2022, 2022, 5816063. [Google Scholar] [CrossRef]
- Manoharan, M. Research on the frontiers of materials science: The impact of nanotechnology on new material development. Technol. Soc. 2008, 30, 401–404. [Google Scholar] [CrossRef]
- Talebian, S.; Rodrigues, T.; Das Neves, J.; Sarmento, B.; Langer, R.; Conde, J. Facts and figures on materials science and nanotechnology progress and investment. ACS Nano 2021, 15, 15940–15952. [Google Scholar] [CrossRef] [PubMed]
- Gopal, J.; Wu, H.-F.; Gangaraju, G. Quantifying the degradation of extracellular polysaccharides of Escherichia coli by CdS quantum dots. J. Mater. Chem. 2011, 21, 13445–13451. [Google Scholar] [CrossRef]
- Gedda, G.; Chen, G.-R.; Yao, Y.-Y.; Girma, W.M.; Li, J.-D.; Yen, C.-L.; Ling, Y.-C.; Chang, J.-Y. Aqueous synthesis of dual-targeting Gd-doped CuInS2/ZnS quantum dots for cancer-specific bi-modal imaging. New J. Chem. 2017, 41, 14161–14170. [Google Scholar] [CrossRef]
- Garg, R.; Rani, P.; Garg, R.; Khan, M.A.; Khan, N.A.; Khan, A.H.; Américo-Pinheiro, J.H.P. Biomedical and catalytic applications of agri-based biosynthesized silver nanoparticles. Environ. Pollut. 2022, 310, 119830. [Google Scholar] [CrossRef] [PubMed]
- Sharma, D.; Kanchi, S.; Bisetty, K. Biogenic synthesis of nanoparticles: A review. Arab. J. Chem. 2019, 12, 3576–3600. [Google Scholar] [CrossRef]
- Iravani, S.; Korbekandi, H.; Mirmohammadi, S.V.; Zolfaghari, B. Synthesis of silver nanoparticles: Chemical, physical and biological methods. Res. Pharm. Sci. 2014, 9, 385. [Google Scholar]
- Ghorbani, H.R.; Safekordi, A.A.; Attar, H.; Sorkhabadi, S. Biological and non-biological methods for silver nanoparticles synthesis. Chem. Biochem. Eng. Q. 2011, 25, 317–326. [Google Scholar]
- Alaqad, K.; Saleh, T.A. Gold and silver nanoparticles: Synthesis methods, characterization routes and applications towards drugs. J. Environ. Anal. Toxicol. 2016, 6, 525–2161. [Google Scholar] [CrossRef]
- Khan, S.H. Green nanotechnology for the environment and sustainable development. In Green Materials for Wastewater Treatment; Springer: Cham, Germany, 2020; pp. 13–46. [Google Scholar]
- Khan, F.; Shariq, M.; Asif, M.; Siddiqui, M.A.; Malan, P.; Ahmad, F. Green nanotechnology: Plant-mediated nanoparticle synthesis and application. Nanomaterials 2022, 12, 673. [Google Scholar] [CrossRef]
- Talib, A.; Khan, M.S.; Gedda, G.; Wu, H.-F. Stabilization of gold nanoparticles using natural plant gel: A greener step towards biological applications. J. Mol. Liq. 2016, 220, 463–467. [Google Scholar] [CrossRef]
- Cuong, H.N.; Pansambal, S.; Ghotekar, S.; Oza, R.; Hai, N.T.T.; Viet, N.M.; Nguyen, V.-H. New frontiers in the plant extract mediated biosynthesis of copper oxide (CuO) nanoparticles and their potential applications: A review. Environ. Res. 2022, 203, 111858. [Google Scholar] [CrossRef] [PubMed]
- Sharma, V.K.; Yngard, R.A.; Lin, Y. Silver nanoparticles: Green synthesis and their antimicrobial activities. Adv. Colloid Interface Sci. 2009, 145, 83–96. [Google Scholar] [CrossRef]
- Venkatadri, B.; Shanparvish, E.; Rameshkumar, M.; Arasu, M.V.; Al-Dhabi, N.A.; Ponnusamy, V.K.; Agastian, P. Green synthesis of silver nanoparticles using aqueous rhizome extract of Zingiber officinale and Curcuma longa: In-vitro anti-cancer potential on human colon carcinoma HT-29 cells. Saudi J. Biol. Sci. 2020, 27, 2980–2986. [Google Scholar] [CrossRef] [PubMed]
- Wei, S.; Wang, Y.; Tang, Z.; Hu, J.; Su, R.; Lin, J.; Zhou, T.; Guo, H.; Wang, N.; Xu, R. A size-controlled green synthesis of silver nanoparticles by using the berry extract of Sea Buckthorn and their biological activities. New J. Chem. 2020, 44, 9304–9312. [Google Scholar] [CrossRef]
- Gilbert, M. A review of Pehr Forsskål’s stapeliads and the typification of Caralluma quadrangula and C. subulata (Asclepiadaceae). Bradleya 1989, 1989, 79–83. [Google Scholar] [CrossRef]
- Masrahi, Y.S.; Al-Turki, T.A.; Sayed, O.H. Crassulacean Acid Metabolism Permutation and Survival of Caralluma Species (Apocynaceae) in Arid Habitats. Ecol. Balk. 2012, 4, 63–71. [Google Scholar]
- Sharawy, S.; Kamel, E.; Karakish, E.; Loutfy, M. A systematic revision on Caralluma species of Saudi Arabia based on karyological and molecular data. Pak. J. Bot 2015, 47, 937–950. [Google Scholar]
- Ramesh, M.; Rao, Y.N.; Kumar, M.R.; Rao, A.V.N.A.; Prabhakar, M.; Reddy, B.M. Antinociceptive and anti-inflammatory activity of carumbelloside-I isolated from Caralluma umbellata. J. Ethnopharmacol. 1999, 68, 349–352. [Google Scholar] [CrossRef]
- Zakaria, M.; Islam, M.; Radhakrishnan, R.; Chen, H.; Kamil, M.; Al-Gifri, A.; Chan, K.; Al-Attas, A. Anti-nociceptive and anti-inflammatory properties of Caralluma arabica. J. Ethnopharmacol. 2001, 76, 155–158. [Google Scholar] [CrossRef]
- Albers, F.; Meve, U. Illustrated Handbook of Succulent Plants: Asclepiadaceae: Asclepiadaceae; Springer Science & Business Media: Berlin/Heidelberg, Germany, 2002. [Google Scholar]
- Ansari, B.; Behl, T.; Pirzada, A.S.; Khan, H. Caralluma edulis (Apocynaceae): A comprehensive review on its traditional uses, phytochemical profile and pharmacological effects. Curr. Top. Med. Chem. 2022, 22, 1501–1514. [Google Scholar] [CrossRef]
- Alqahtani, S.S.; Makeen, H.A.; Menachery, S.J.; Moni, S.S. Documentation of bioactive principles of the flower from Caralluma retrospiciens (Ehrenb) and in vitro antibacterial activity—Part B. Arab. J. Chem. 2020, 13, 7370–7377. [Google Scholar] [CrossRef]
- Alamier, W.M.; Hasan, N.; Ali, S.K.; Oteef, M.D.Y. Biosynthesis of Ag nanoparticles using Caralluma acutangula extract and its catalytic functionality towards degradation of hazardous dye pollutants. Crystals 2022, 12, 1069. [Google Scholar] [CrossRef]
- Naseem, K.; Zia Ur Rehman, M.; Ahmad, A.; Dubal, D.; AlGarni, T.S. Plant extract induced biogenic preparation of silver nanoparticles and their potential as catalyst for degradation of toxic dyes. Coatings 2020, 10, 1235. [Google Scholar] [CrossRef]
- Kim, B.; Song, W.C.; Park, S.Y.; Park, G. Green synthesis of silver and gold nanoparticles via Sargassum serratifolium extract for catalytic reduction of organic dyes. Catalysts 2021, 11, 347. [Google Scholar] [CrossRef]
- Litvin, V.A.; Minaev, B.F. Spectroscopy study of silver nanoparticles fabrication using synthetic humic substances and their antimicrobial activity. Spectrochim. Acta Part A Mol. Biomol. Spectrosc. 2013, 108, 115–122. [Google Scholar] [CrossRef]
- Kora, A.J.; Sashidhar, R.; Arunachalam, J. Aqueous extract of gum olibanum (Boswellia serrata): A reductant and stabilizer for the biosynthesis of antibacterial silver nanoparticles. Process Biochem. 2012, 47, 1516–1520. [Google Scholar] [CrossRef]
- Siddiqui, M.R.H.; Adil, S.; Assal, M.; Ali, R.; Al-Warthan, A. Synthesis and characterization of silver oxide and silver chloride nanoparticles with high thermal stability. Asian J. Chem. 2013, 25, 3405–3409. [Google Scholar] [CrossRef]
- Ostovar, F.; Ansari, R.; Moafi, H. Preparation and application of silver oxide/sawdust nanocomposite for Chromium (VI) ion removal from aqueous solutions using column system. Glob. Nest J. 2017, 19, 412–422. [Google Scholar]
- Alamier, W.M.; Oteef, D.Y.M.; Bakry, A.M.; Hasan, N.; Ismail, K.S.; Awad, F.S. Green Synthesis of Silver Nanoparticles Using Acacia ehrenbergiana Plant Cortex Extract for Efficient Removal of Rhodamine B Cationic Dye from Wastewater and the Evaluation of Antimicrobial Activity. ACS Omega 2023, 8, 18901–18914. [Google Scholar] [CrossRef]
- Adebayo-Tayo, B.; Salaam, A.; Ajibade, A. Green synthesis of silver nanoparticle using Oscillatoria sp. extract, its antibacterial, antibiofilm potential and cytotoxicity activity. Heliyon 2019, 5, e02502. [Google Scholar] [CrossRef] [PubMed]
- Alamier, W.M.; Hasan, N.; Nawaz, M.D.S.; Ismail, K.S.; Shkir, M.; Malik, M.A.; Oteef, M.D.Y. Biosynthesis of NiFe2O4 nanoparticles using Murayya koenigii for photocatalytic dye degradation and antibacterial application. J. Mater. Res. Technol. 2023, 22, 1331–1348. [Google Scholar] [CrossRef]
- David, L.; Moldovan, B. Green synthesis of biogenic silver nanoparticles for efficient catalytic removal of harmful organic dyes. Nanomaterials 2020, 10, 202. [Google Scholar] [CrossRef] [PubMed]
- Manikandan, V.; Velmurugan, P.; Park, J.-H.; Chang, W.-S.; Park, Y.-J.; Jayanthi, P.; Cho, M.; Oh, B.-T. Green synthesis of silver oxide nanoparticles and its antibacterial activity against dental pathogens. 3 Biotech 2017, 7, 72. [Google Scholar] [CrossRef] [PubMed]
- Raj, S.; Singh, H.; Trivedi, R.; Soni, V. Biogenic synthesis of AgNPs employing Terminalia arjuna leaf extract and its efficacy towards catalytic degradation of organic dyes. Sci. Rep. 2020, 10, 9616. [Google Scholar] [CrossRef] [PubMed]
- Jawhari, A.H.; Hasan, N.; Radini, I.A.; Malik, M.A.; Narasimharao, K. Pt-Ag/Ag3PO4-WO3 nanocomposites for photocatalytic H2 production from bioethanol. Fuel 2023, 344, 127998. [Google Scholar] [CrossRef]
- Vadlapudi, V.; Amanchy, R. Phytofabrication of silver nanoparticles using Myriostachya wightiana as a novel bioresource, and evaluation of their biological activities. Braz. Arch. Biol. Technol. 2017, 60. [Google Scholar] [CrossRef]
- Premanand, G.; Shanmugam, N.; Kannadasan, N.; Sathishkumar, K.; Viruthagiri, G. Nelumbo nucifera leaf extract mediated synthesis of silver nanoparticles and their antimicrobial properties against some human pathogens. Appl. Nanosci. 2016, 6, 409–415. [Google Scholar] [CrossRef][Green Version]
- Gola, D.; Kriti, A.; Bhatt, N.; Bajpai, M.; Singh, A.; Arya, A.; Chauhan, N.; Srivastava, S.K.; Tyagi, P.K.; Agrawal, Y. Silver nanoparticles for enhanced dye degradation. Curr. Res. Green Sustain. Chem. 2021, 4, 100132. [Google Scholar] [CrossRef]
- Saha, P.; Mahiuddin, M.; Islam, A.N.; Ochiai, B. Biogenic synthesis and catalytic efficacy of silver nanoparticles based on peel extracts of citrus macroptera fruit. ACS Omega 2021, 6, 18260–18268. [Google Scholar] [CrossRef]
- Essa, A.M.M.; Al Abboud, M.A.; Khatib, S.I. Metal transformation as a strategy for bacterial detoxification of heavy metals. J. Basic Microbiol. 2018, 58, 17–29. [Google Scholar] [CrossRef]

| Monolayer Adsorption Volume, Vm (cm3 (STP) g−1) | Constant, C | BET Surface Area (m2g−1) |
|---|---|---|
| 3.4917 | 37.484 | 15.198 |
| Cumulative Surface Area of Pore, SBJH (m2 g−1) | Cumulative Pore Volume of Pore, VBJH (cm3·g−1) | Average Pore Diameter, dBJH (nm) |
|---|---|---|
| 27.105 | 0.123 | 18.15 |
| S. No. | Chemical Kinetic Model | Linear Equations Model | Regression Coefficient (R2) Value | Rate Constant (k) |
|---|---|---|---|---|
| 1 | Zero order | 0.9380 | 0.0508 (mol L−1 min−1) | |
| 2 | First order | 0.8145 | 0.1131 (min−1) | |
| 3 | Second order | 0.6541 | 0.4051 (L mol−1 min−1) |
| Sr. No | Name of Microorganism | Gram Character | Concentrations of Ag-CS NPs Used (mg/mL) | Controls Used | ||||||
|---|---|---|---|---|---|---|---|---|---|---|
| 30 | 25 | 20 | 15 | 10 | 5 | Plant Extract (PC) | Antibiotic Control (AC) Va (30 μg)/Gat (5 μg) | |||
| Zone of Inhibition (mm) | ||||||||||
| Md 1 | Staphylococcus aureus | +ve | 29 | 26 | 20 | 18 | 18 | 14 | 10 | 12 |
| Md 2 | MRSA–1 | +ve | 21 | 20 | 19 | 17 | 16 | 0 | 9 | 12 |
| Md 3 | MRSA–2 | +ve | 16 | 14 | 0 | 0 | 0 | 0 | 0 | 12 |
| Md 4 | MRSA–3 | +ve | 15 | 14 | 12 | 0 | 0 | 0 | 9 | 10 |
| Md 5 | MRSA–4 | +ve | 17 | 15 | 14 | 13 | 0 | 0 | 10 | 11 |
| Md 6 | MRSA–5 | +ve | 17 | 16 | 12 | 11 | 0 | 0 | 9 | 10 |
| Md 7 | MRSA–6 | +ve | 16 | 14 | 14 | 13 | 11 | 0 | 0 | 12 |
| Md 8 | MRSA–7 | +ve | 18 | 17 | 15 | 14 | 12 | 0 | 0 | 12 |
| Md 9 | MRSA–8 | +ve | 18 | 17 | 14 | 12 | 12 | 11 | 10 | 9 |
| Md 10 | Staphylococcus epidermidis | +ve | 24 | 22 | 20 | 19 | 17 | 11 | 0 | 0 |
| Md 11 | Alcaligenes faecalis | −ve | 22 | 18 | 14 | 0 | 11 | 10 | 9 | 18 |
| Md 12 | Staphylococcus xylosus | +ve | 16 | 14 | 12 | 0 | 0 | 0 | 0 | 11 |
| Md 13 | Klebsiella pneumoniae | −ve | 18 | 17 | 15 | 12 | 0 | 0 | 9 | 14 |
| Md 14 | Escherichia coli | −ve | 18 | 16 | 14 | 13 | 12 | 0 | 9 | 28 |
| Md 15 | Staphylococcus saprophyticus | +ve | 14 | 13 | 12 | 11 | 12 | 0 | 0 | 11 |
| Md 16 | Pseudomonas aeruginosa | −ve | 20 | 18 | 17 | 15 | 13 | 0 | 9 | 19 |
| Md 17 | Candida albicans (Fungi) | +ve | 12 | 11 | 11 | 10 | 10 | 0 | 9 | 27 |
| Md 18 | Staphylococcus aureus ATCC | +ve | 20 | 17 | 15 | 14 | 12 | 11 | 0 | 12 |
| Md 19 | Morganella morganii | −ve | 25 | 21 | 20 | 17 | 20 | 16 | 9 | 12 |
Disclaimer/Publisher’s Note: The statements, opinions and data contained in all publications are solely those of the individual author(s) and contributor(s) and not of MDPI and/or the editor(s). MDPI and/or the editor(s) disclaim responsibility for any injury to people or property resulting from any ideas, methods, instructions or products referred to in the content. |
© 2023 by the authors. Licensee MDPI, Basel, Switzerland. This article is an open access article distributed under the terms and conditions of the Creative Commons Attribution (CC BY) license (https://creativecommons.org/licenses/by/4.0/).
Share and Cite
Alamier, W.M.; Hasan, N.; Syed, I.S.; Bakry, A.M.; Ismail, K.S.; Gedda, G.; Girma, W.M. Silver Nanoparticles’ Biogenic Synthesis Using Caralluma subulata Aqueous Extract and Application for Dye Degradation and Antimicrobials Activities. Catalysts 2023, 13, 1290. https://doi.org/10.3390/catal13091290
Alamier WM, Hasan N, Syed IS, Bakry AM, Ismail KS, Gedda G, Girma WM. Silver Nanoparticles’ Biogenic Synthesis Using Caralluma subulata Aqueous Extract and Application for Dye Degradation and Antimicrobials Activities. Catalysts. 2023; 13(9):1290. https://doi.org/10.3390/catal13091290
Chicago/Turabian StyleAlamier, Waleed M., Nazim Hasan, Imam Saheb Syed, Ayyob M. Bakry, Khatib Sayeed Ismail, Gangaraju Gedda, and Wubshet Mekonnen Girma. 2023. "Silver Nanoparticles’ Biogenic Synthesis Using Caralluma subulata Aqueous Extract and Application for Dye Degradation and Antimicrobials Activities" Catalysts 13, no. 9: 1290. https://doi.org/10.3390/catal13091290
APA StyleAlamier, W. M., Hasan, N., Syed, I. S., Bakry, A. M., Ismail, K. S., Gedda, G., & Girma, W. M. (2023). Silver Nanoparticles’ Biogenic Synthesis Using Caralluma subulata Aqueous Extract and Application for Dye Degradation and Antimicrobials Activities. Catalysts, 13(9), 1290. https://doi.org/10.3390/catal13091290

